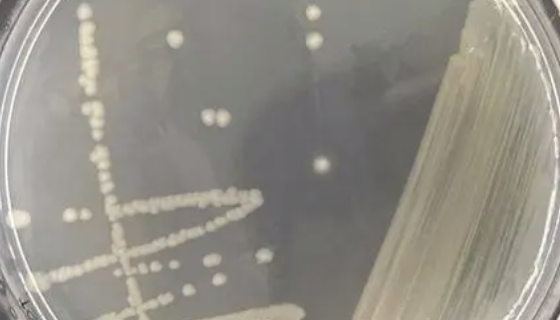
需钠弧菌的培养方法与实验内容及打管说明！
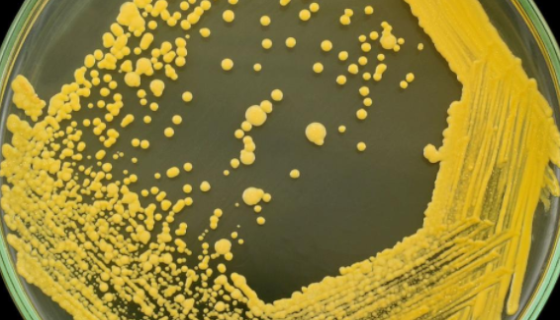
ATCC 49129 皮氏罗尔斯顿菌 百欧博伟生物

细胞培养基中常见添加剂的功能及使用方法!
细胞培养过程中,细胞培养基是不可或缺的,细胞培养基既是培养细...
需钠弧菌的培养方法与实验内容及打管说明!
需钠弧菌常用于实验和科研检测用,属于菌株类。

大鼠胸主动脉平滑肌细胞的处理方法与培养步骤!
大鼠胸主动脉平滑肌细胞用于无菌离心管收集瓶子培养基,留作过渡...

嗜热脂肪地芽孢杆菌的性质与用途及生产工艺!
嗜热脂肪地芽孢杆菌(Bacillusstearothermo...

L Wnt-3A(小鼠皮下结缔组织细胞)培养操作规程!
L Wnt-3A(小鼠皮下结缔组织细胞)的处理方法与培养操作...
ATCC 49129 皮氏罗尔斯顿菌 百欧博伟生物
皮氏罗尔斯顿菌是Ralstonia属的微生物,原产地为中国。...

B16-OVA小鼠黑色素瘤细胞(鸡OVA基因修饰)
小鼠黑色素瘤细胞(鸡OVA基因修饰)的培养步骤及验收注意事项...

HOK人正常口腔角质细胞的培养方式与质量检测!
人正常口腔角质细胞的培养方式与质量检测及注意事项有哪些?

巴尼伯德新鞘氨醇菌的特征与培养及打管说明!
巴尼伯德新鞘氨醇菌是Novosphingobium属的微生物...